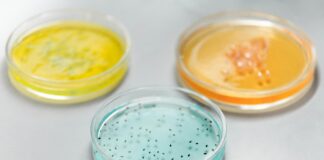
Clinical Pathology Laboratories: Unlocking Secrets Behind Accurate Diagnoses

Tag: Mayo Clinic services
Mayo Clinic Near Me: Discover Trusted Care Options Close By
Looking for a Mayo Clinic near me? Wondering where to find the most trusted and comprehensive healthcare options close by? You're not alone! Many...
Mayo Clinic La Crosse: Discover Expert Care and Amazing Services
Are you looking for world-class healthcare in the heart of Wisconsin? Look no further than Mayo Clinic La Crosse, a top destination for cutting-edge...